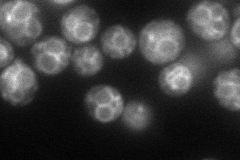
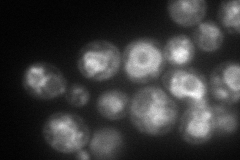
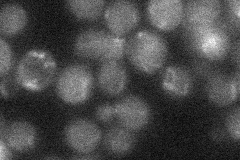
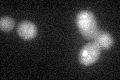
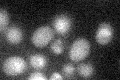

View description
Phosphatidylinositol 4,5-bisphosphate 5-phosphatase with a role in secretion, localizes to the endoplasmic reticulum via the C-terminal tail; lacks the Sac1 domain and proline-rich region found in the other 3 INP proteins
Localization:
Intensity:
Fold change:
Significance:
-
C’ GFP library in SD

cytosol20.35 -
N' NOP1pr-GFP in SD
vacuole membrane85.7666 -
N' TEF2pr-mCherry in SD
vacuole membrane124.887 -
N' NATIVEpr-GFP in SD
below threshold19.8522 -
N' TEF2pr-VC and Cyto-VN in SD

vacuole membrane35.6656 -
C’ GFP library in SD+DTT
cytosol15.660.76No -
C’ GFP library in SD+H2O2

cytosol17.720.87No -
C’ GFP library in Starvation Media
cytosol25.611.25No -
C’ GFP library on the background of Pup2-DaMP

cytosol -
C’ GFP library on the background of CCT mutant

cytosol18.44370.906275No
